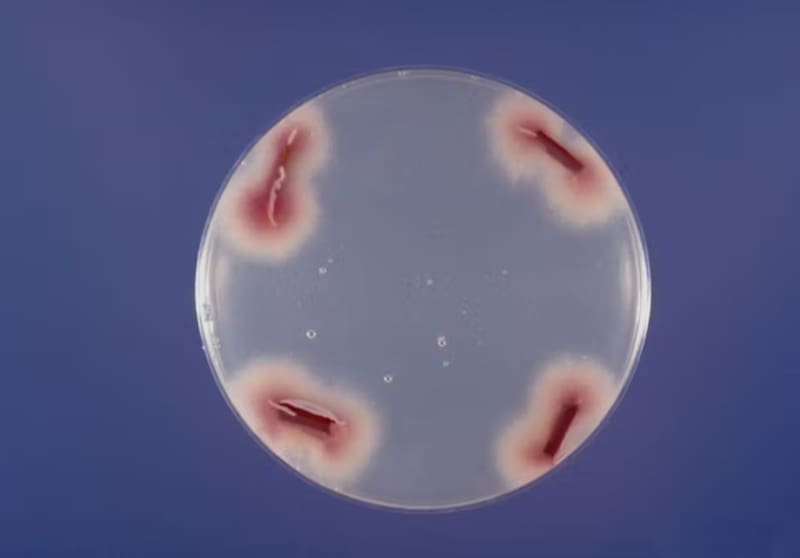

¿Qué es el “Apocalipsis del plátano”?: el fenómeno que está devastando esta fruta en todo el mundo
Un genómico explica los extraños detalles de este ataqte que atenta contra extensas plantaciones de bananos alrededor del planeta.

¿Sabías que los plátanos que comes hoy no son del mismo tipo que los que la gente comía hace unas generaciones? El plátano que podría haber tomado con su desayuno hoy es una variedad llamada plátano Cavendish, mientras que el que estaba en las tiendas de comestibles hasta la década de 1950 era una variedad llamada Gros Michel, que fue eliminada por una enfermedad llamada marchitez por Fusarium del plátano, o FWB.
La FWB de Gros Michel fue causada por Fusarium oxysporum raza 1, un patógeno fúngico que afecta a los plátanos. Esta infección fúngica mata a una planta ocupando su sistema vascular, bloqueando el transporte de agua y minerales.
Apocalipsis del plátano: el extraño hongo que devasta este cultivo en todo el mundo
Los biólogos de plantas desarrollaron la variedad Cavendish resistente al Fusarium para reemplazar al Gros Michel. Sin embargo, en las últimas décadas, un resurgimiento de FWB causado por una cepa diferente del mismo hongo llamada raza tropical 4, o TR4, está amenazando una vez más la producción mundial de banano.

¿Cómo adquirió Fusarium oxysporum la capacidad de vencer la resistencia e infectar tantas plantas diferentes? Soy un genómico que ha pasado la última década estudiando la evolución genética de Fusarium oxysporum. Como complejo de especies, F. oxysporum puede causar enfermedades de marchitez y pudrición de la raíz en más de 120 especies de plantas. Ciertas cepas también pueden infectar a las personas.
En 2010, mi laboratorio descubrió que cada genoma de F. oxysporum se puede dividir en dos partes: un genoma central compartido entre todas las cepas que codifica funciones esenciales de limpieza, y un genoma accesorio que varía de una cepa a otra y que codifica funciones especializadas como la capacidad de infectar a una planta huésped específica.
Cada especie de planta tiene una respuesta inmunitaria sofisticada para defenderse de la invasión microbiana. Por lo tanto, para establecer una infección, cada cepa de F. oxysporum utiliza su genoma accesorio para suprimir el sistema de defensa único de una planta. Esta compartimentación funcional permite a F. oxysporum aumentar en gran medida su rango de huéspedes.
En nuestra investigación recién publicada, mi equipo y colegas en China y Sudáfrica descubrieron que la cepa TR4 que mata a los plátanos Cavendish tiene un origen evolutivo diferente y diferentes secuencias en su genoma accesorio en comparación con la cepa que mató a los plátanos Gros Michel.
Al observar la interfaz en la que la cepa TR4 está luchando con su huésped de plátano Cavendish, descubrimos que algunos de sus genes accesorios activados liberan óxido nítrico, un gas dañino para el plátano Cavendish. Esta explosión repentina de gases tóxicos facilita la infección al desarmar el sistema de defensa de la planta. Al mismo tiempo, el hongo se protege aumentando la producción de productos químicos que desintoxican el óxido nítrico.
Aumento de la diversidad del banano
Al rastrear la propagación mundial de esta nueva versión de Fusarium oxysporum, nos dimos cuenta de que una de las principales causas del reciente resurgimiento de esta infección fúngica es el dominio de la industria internacional del banano por un solo clon de banano.
El cultivo de diferentes variedades de banano puede hacer que la agricultura sea más sostenible y reducir la presión de las enfermedades en un solo cultivo. Los agricultores e investigadores pueden controlar el marchitamiento por Fusarium del banano identificando o desarrollando variedades de banano que sean tolerantes o resistentes a la TR4. Nuestros hallazgos sugieren que otra forma de proteger los plátanos Cavendish sería diseñar eliminadores de óxido nítrico efectivos para reducir la presión tóxica de la explosión de gas.
Puede ser difícil imaginar cómo un consumidor que simplemente disfruta comiendo plátanos podría participar en la batalla contra la enfermedad que devasta los cultivos de plátanos. Sin embargo, los consumidores determinan el mercado, y los agricultores se ven obligados a cultivar lo que el mercado demanda.
Puede ayudar a aumentar la diversidad de plátanos en su supermercado probando intencionalmente una o más de las otras cientos de otras variedades de plátanos existentes cuando aparezcan allí. También puede comprar variedades locales de otras frutas y productos agrícolas para ayudar a preservar la diversidad de plantas y apoyar a los productores locales.

La colaboración entre científicos, agricultores, industria y consumidores de todo el mundo puede ayudar a evitar futuras escaseces de plátanos y otros cultivos.
*Li-Jun Ma es profesor de Bioquímica y Biología Molecular, de la Universidad de Massachusetts Amherst.
Lea también en Qué Pasa:
COMENTARIOS
Para comentar este artículo debes ser suscriptor.
Lo Último
Lo más leído
Plan digital + LT Beneficios por 3 meses
Navidad con buen periodismo, descuentos y experiencias🎄$3.990/mes SUSCRÍBETE













